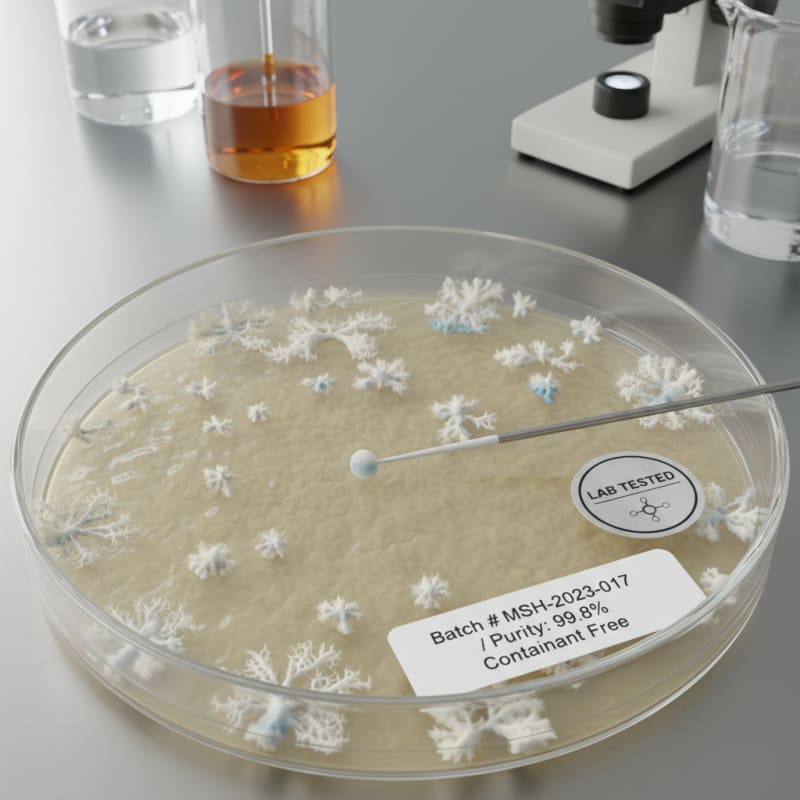
lab tested mushroom products illustration 3

What "Lab Tested" Actually Means for Mushroom Products
Quick Summary
Real lab testing means measured potency via HPLC or LC-MS/MS, contaminant screening, and a batch-linked Certificate of Analysis. Without documentation, "lab tested" is a marketing phrase.

"Lab tested" is one of the most common phrases used in mushroom ecommerce.
It sounds reassuring. It implies measurement, safety, and control.
But in practice, that phrase can mean very different things depending on what was actually tested, how it was tested, and whether the results are accessible.
1. Potency Testing
The primary purpose of laboratory testing for psilocybin-containing mushrooms is potency measurement.
Modern labs use analytical chemistry methods such as High Performance Liquid Chromatography (HPLC) and Liquid Chromatography with Tandem Mass Spectrometry (LC-MS/MS). Learn more about how potency is actually measured.
Without potency testing, "3.5 grams" only describes weight, not chemical content.
2. Identity Verification
Laboratories may also verify species identity. This helps confirm that the material being sold is the species it claims to be.
3. Contaminant Screening
Mushrooms can accumulate contaminants from their growing environment. Comprehensive safety panels may test for heavy metals, microbial contamination, pesticide residues, mycotoxins, and residual solvents.
4. Certificate of Analysis
When testing is legitimate, it produces a Certificate of Analysis (COA).
A Certificate of Analysis is only meaningful if it is tied to a specific batch. If a website claims lab testing but does not provide a batch-linked COA, the claim cannot be independently verified.
5. What Lab Testing Does Not Guarantee
Lab testing confirms that a specific sample contained specific measured values at the time of testing.
It does not guarantee that every unit in the batch is chemically identical, that storage conditions after testing did not degrade potency, or that future batches will match past results.
6. Why This Matters
In mushroom products, weight alone is not precision.
Potency measurement allows for consistent dosing, especially in capsules, chocolates, or segmented bars.
When "lab tested" is real, it means the product has been measured using recognized analytical chemistry methods and the results are documented.
When it is vague, it usually means the documentation is missing.
The difference is not emotional. It is procedural.
And in this category, procedure is the difference between assumption and verification.
ShroomDash Editorial Team
Published 2026-02-15 · 8 min read · Lab Science



